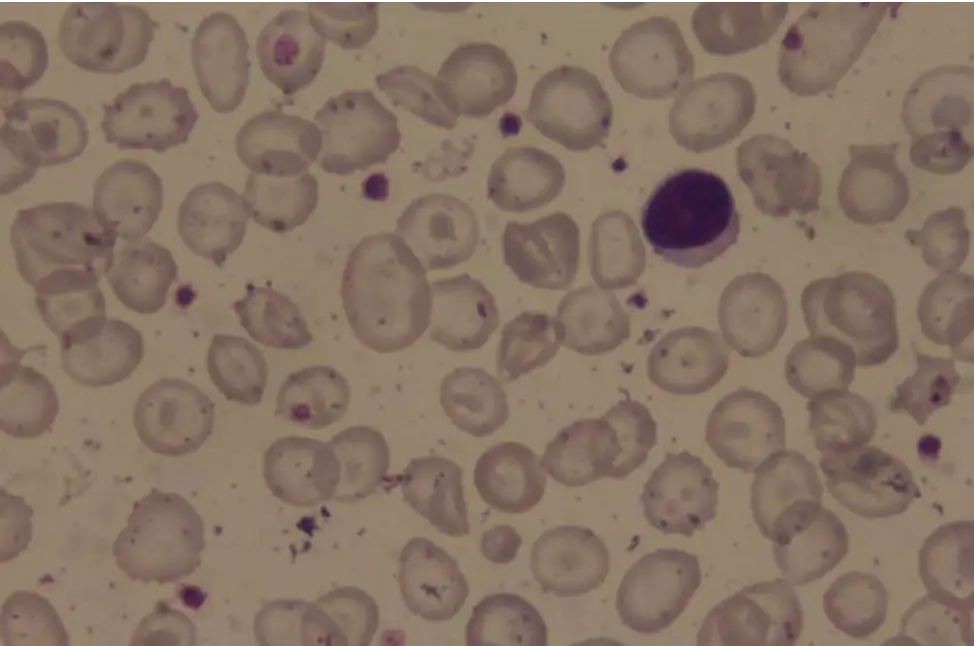
圖片描述

106年:內專
一位23歲病人因呼吸急促應診,血液檢查顯示血紅素為6.3 g/dL,血小板、白血球及分類正常,網狀紅血球(reticulocyte) 3.5%,全膽紅素 (total bilirubin) 3.4 mg/dL,直接膽紅素 (direct bilirubim) 0.7 mg/dL;血液抹片如圖所示。此位病人最可能得了什麼病?
AIron deficiency anemia
BAutoimmune hemolytic anemia
CVit B12 deficiency anemia
DThalassemia
EG6PD deficiency
詳細解析
本題觀念:
本題聚焦於慢性溶血性微球低色素性貧血的診斷,特別是 Thalassemia 的血液學特徵,包括末梢血抹片所見的典型紅血球形態改變與實驗室數值。
影像分析:
從末梢血抹片可見:
- 大量微小、低色素 (hypochromic) 的紅血球,顯示 MCV 下降、MCH 下降。
- 明顯的 target cells(codocytes):紅血球邊緣及中央沉積血紅素,呈牛眼狀,為典型於 Thalassemia 及某些血色素異常的表徵。
- 個別可見 poikilocytosis(大小形不一)及少許 nucleated RBC,暗示外周血有未成熟紅血球釋放,符合慢性溶血或有效率升高的骨髓增生狀態。
- 未見 spherocytes、bite cells 或巨紅血球等其他異常形態。
這些形態學改變指向一種慢性、遺傳性、以 microcytosis 與 hemolysis 為主的血紅素病。
選項分析
-
選項A Iron deficiency anemia
雖可造成 microcytic hypochromic anemia,但末梢血典型為 pencil cells 而非大量 target cells;且常伴鐵指標下降,無明顯間歇性溶血表徵(indirect bilirubin 不會這麼高)。
排除。 -
選項B Autoimmune h
...(解析預覽)...

升級 VIP 解鎖圖文解析